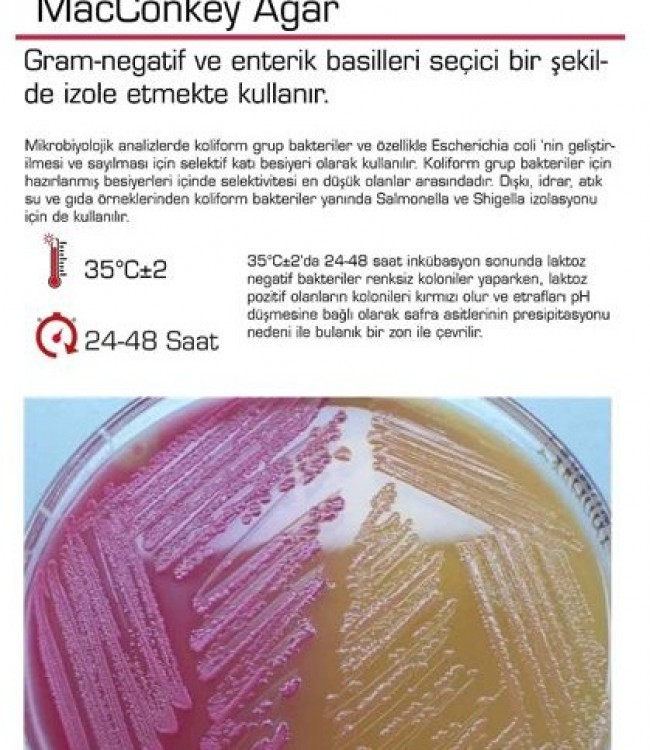
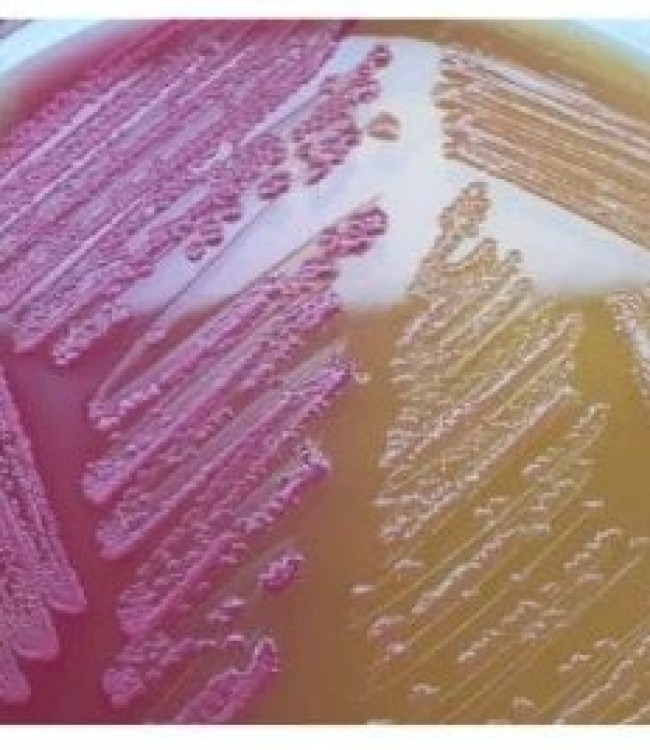

MacConkey Agar
MacConkey Agar
Gram-negatif ve enterik basilleri seçici bir şekilde izole etmekte kullanır.
Mikrobiyolojik analizlerde koliform grup bakteriler ve özellikle Escherichia coli 'nin geliştirilmesi ve sayılması için selektif katı besiyeri olarak kullanılır.
Koliform grup bakteriler için hazırlanmış besiyerleri icinde selektivitesi en düşük olanlar arasındadır.
Dışkı, idrar, atık su ve gıda örneklerinden koliform bakteriler yanında Salmonella ve Shigella izolasyonu için de kullanılır.
35 C'de 18-24 saat inkübasyon sonunda laktoz negatif bakteriler renksiz koloniler yaparken, laktoz pozitif olanların kolonileri kırmızı olur ve etrafları pH düşmesine bağlı olarak safra asitlerinin presipitasyonu nedeni ile bulanık bir zon ile çevrilir.